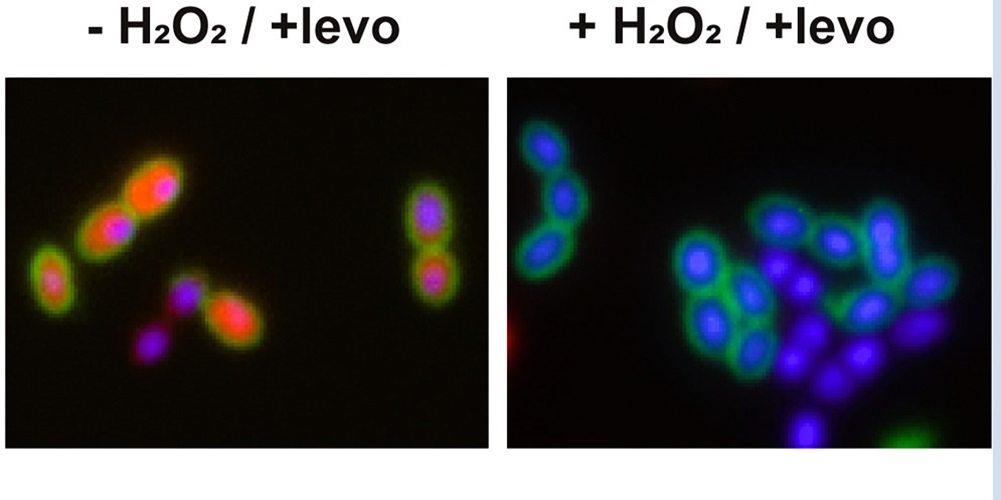

Especialistas del CONICET revelaron que la exposición al estrés oxidativo intracelular podría inducir la tolerancia de subpoblaciones de esta bacteria al tratamiento con altas concentraciones de fluoroquinolonas.
Streptococcus pneumoniae, comúnmente llamado neumococo, es una bacteria patogénica que se encuentra en la nasofaringe humana (sobre todo en niñas y niños) y puede causar desde enfermedades leves, como otitis o sinusitis, hasta patologías más severas, como neumonía y meningitis. A pesar de que existen vacunas para prevenir las infecciones causadas por este patógeno, así como diferentes antibióticos para tratarlas, se estima que este tipo de enfermedades ocasionan más de un millón de muertes anuales en todo el mundo. Esta situación convierte al neumococo en el agente patógeno que más muertes causa entre aquellos que producen enfermedades infecciosas prevenibles por vacunas. La eficacia de los diferentes antibióticos disponibles para tratar el neumococo se ve en la actualidad críticamente comprometida por la aparición de distintas cepas que desarrollan tolerancia, persistencia o resistencia a determinados tratamientos farmacológicos. En este sentido, ya se ha establecido la existencia de mecanismos de tolerancia a la vancomicina, así como de resistencia a la penicilina y al grupo de antibióticos conocido como fluoroquinolonas.
De manera reciente, científicos y científicas del CONICET presentaron una investigación en la que muestran, a partir de ensayos en modelos celulares, que la exposición al estrés oxidativo intracelular podría llevar a que pequeñas poblaciones del neumococo desarrollen mecanismos de persistencia al tratamiento con fluoroquinolonas. La persistencia es un tipo de tolerancia a altas concentraciones de antibióticos que una subpoblación bacteriana adquiere a partir de factores ambientales y que no se hereda a la descendencia (es decir, que no implica modificaciones en el genoma). Por otra parte, la persistencia del neumococo a las fluoroquinolonas resulta clínicamente relevante, sobre todo, debido a que podría fallar la terapia antibiótica debido a la emergencia de cepas con resistencia a este tipo de antibióticos. En este aspecto, se considera que la persistencia puede ser un paso previo a la aparición de casos de resistencia a antibióticos. El estudio, dirigido por José Echenique, investigador del CONICET en el Centro de Investigaciones en Bioquímica Clínica e Inmunología (CIBICI, CONICET-UNC), fue publicado en la revista Microbiology Spectrum de la Sociedad Americana de Microbiología. La primera autora del estudio fue Mirelys Hernández-Morfa, becaria doctoral del Consejo en el CIBICI.

La vida intracelular del neumococo
Aunque el neumococo vive principalmente en el ámbito extracelular, puede permanecer al interior de células del sistema inmune o de neumocitos (células especializadas que forman los alvéolos pulmonares) de forma transitoria durante varias horas. «Cuando una bacteria ingresa a una célula del sistema inmune, como macrófagos o neutrófilos, se desata un estallido de estrés oxidativo que tiene como objetivo matar al patógeno. Es decir que las células comienzan a producir peróxido de hidrógeno, entre otras especies reactivas de oxígeno, para deshacerse de la infección», explica Echenique.
Ahora bien, aunque la mayoría de bacterias de neumococo mueren debido al ataque de peróxido de hidrógeno, se ha establecido que existe una subpoblación que logra sobrevivir. «El neumococo es una bacteria que tiene fuertes mecanismos de resistencia frente al estrés oxidativo, dado que necesita sobrevivir al propio peróxido de hidrógeno que suele producir para competir con otras bacterias que habitan la nasofaringe, que está tapizada por cerca de setecientos microorganismos diferentes. Si el neumococo no tuviera enzimas que pueden degradar el peróxido de hidrógeno a nivel intracelular, no existiría una subpoblación con posibilidades de sobrevivir al estallido oxidativo que se produce cuando ingresan a una célula humana. Poder sobrevivir a estos niveles de estrés oxidativo es ya un mecanismo bastante sofisticado para un organismo que normalmente es extracelular», afirma el investigador.
Desarrollo de persistencia a las fluoroquinolonas
Las fluoroquinolonas son un grupo de antibióticos que se utilizan para tratar infecciones producidas por neumococo, cuyo mecanismo de acción está también vinculado al aumento de los niveles de estrés oxidativo. Conociendo que la previa exposición a peróxido de hidrógeno induce el mecanismo de defensa del neumococo contra este tipo de compuestos, los autores propusieron que este escenario podría contrarrestar el efecto de las fluoroquinolonas. Esto llevó a que el equipo de investigación que dirige Echenique analizara si la exposición al peróxido de hidrógeno conducía al neumococo a desarrollar mecanismos de persistencia a las fluoroquinolonas, y así lo corroboraron a través de ensayos en medios de cultivos y con diferentes modelos celulares.
«Para determinar si la exposición al estrés oxidativo lo llevaba a desarrollar persistencia a antibióticos, lo primero que hicimos fue exponer al neumococo a un medio de cultivo con cantidades similares de peróxido de hidrógeno a las que podría exponerse al interior de una célula del sistema inmune. Al agregarle fluoroquinolonas vimos que efectivamente se incrementaba en estas bacterias la sobrevida ante este antibiótico, en comparación con lo que sucedió con neumococos que no habían sido expuestas al estrés oxidativo. Logramos además identificar algunos genes que están involucrados en el desarrollo de este mecanismo», señala Echenique.
El paso siguiente fue poner a prueba si este comportamiento se podía reproducir en modelos celulares, tales como macrófagos, neumocitos y neutrófilos.
«En los modelos celulares, como ya sabíamos, el ingreso del neumococo genera un aumento de los niveles de peróxido de hidrógeno al interior de las células, que lleva a que un alto porcentaje de las bacterias mueran, aunque una subpoblación es capaz de sobrevivir. Después de varias horas, le agregamos fluoroquinolonas para ver si la exposición al estrés oxidativo intracelular también producía el desarrollo de un mecanismo de persistencia a este antibiótico, tal como había ocurrido en los ensayos en medios de cultivo. Así, logramos identificar que la inducción del mecanismo de persistencia a las fluoroquinolonas también ocurre cuando el neumococo se expone al estrés oxidativo intracelular cuando invade las células», desarrolla el investigador.
Echenique destaca que este tipo de tolerancia no significa resistencia a antibióticos, porque para ello tiene que haber mutaciones en ciertos genes o incorporación de nuevos genes. «Cuando uno le quita el peróxido de hidrógeno y los trata nuevamente con fluoroquinolonas, las bacterias persistentes recuperan sensibilidad a los antibióticos y mueren».
Además, Echenique aclara: «Este mecanismo de persistencia a antibióticos es relevante desde un punto de vista clínico, ya que disminuiría la eficiencia del tratamiento antimicrobiano de pacientes con infecciones neumocócicas, y, por otra parte, la mayor exposición a las fluoroquinolonas facilitaría la generación de cepas resistentes».
Referencia bibliográfica
Hernández-Morfa, M., Reinoso-Vizcaíno, N. M., Olivero, N. B., Zappia, V. E., Cortes, P. R., Jaime, A., & Echenique, J. (2022). Host Cell Oxidative Stress Promotes Intracellular Fluoroquinolone Persisters of Streptococcus pneumoniae. Microbiology Spectrum, 10(6), e04364-22. https://doi.org/10.1128/spectrum.04364-22